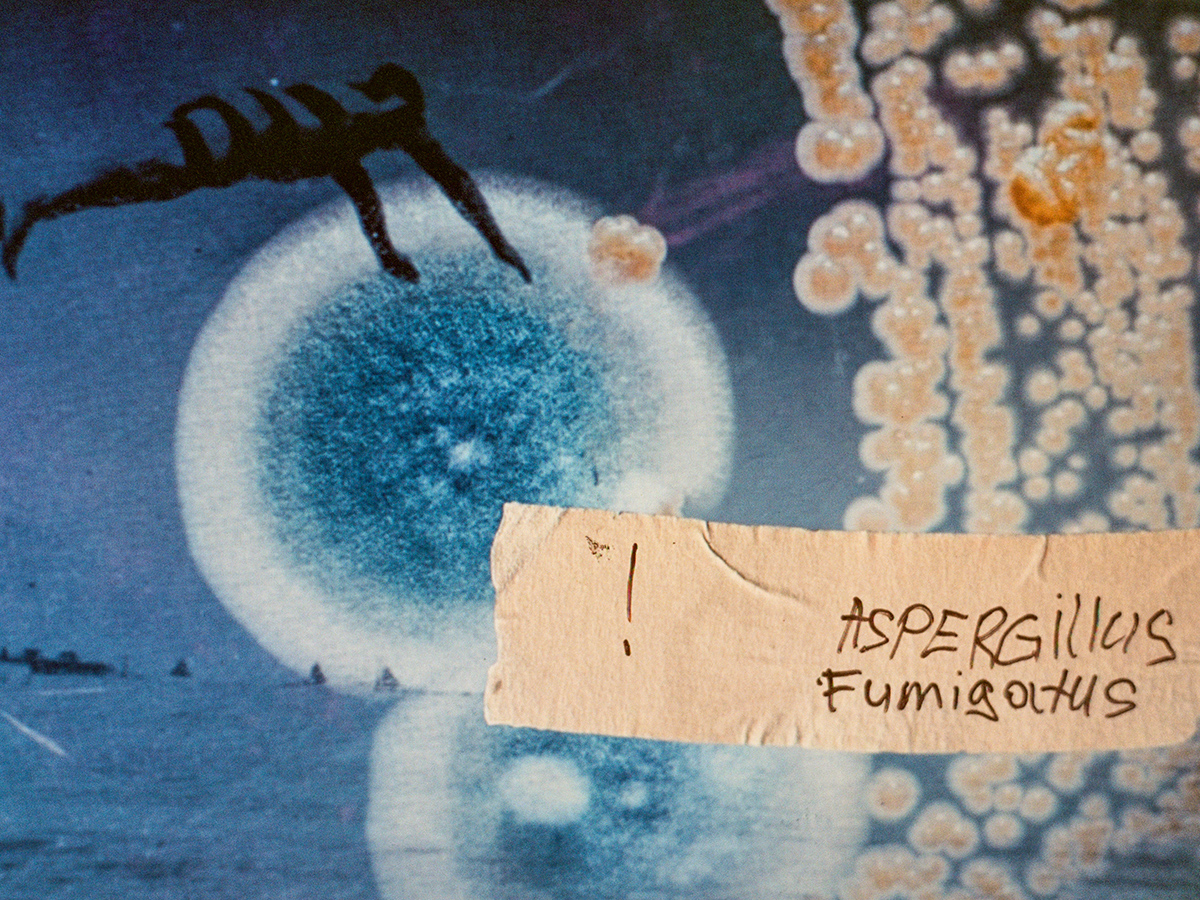

Владислав Андрієвський
Вік Бакін
Льоша Березовський
Мішка Бочкарьов
Аня Брудна
Алекс Бланко
Назар Фурик
Єгор Гущін
Артем Гумілевський
Вадим Івченко
Юрко Калічак
Ксенія Каргіна
Даниїл Котляр
Саша Курмаз
Іра Лупу
Дом Маркер
Микола Майчик
Єгор Паркер
Анатолій Петченко
Кристина Подобед
Олексій Пономарьов
Аліна Прісіч
Джулі Полі
В’ячеслав Поляков
Ірина Шкода
Елена Субач
Synchrodogs
Дарʼя Свертілова
Аня Царук
Даніїл Вайсберг
Василина Врублевська
Ян Васючник
Степан Лісовський
Володимир Камінецький